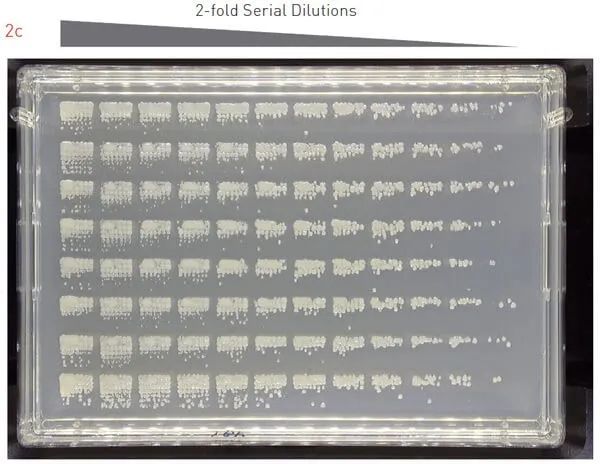

新聞應(yīng)用
更新時(shí)間:2024-09-25 瀏覽次數(shù):1633
自動(dòng)化設(shè)備的發(fā)展有助于實(shí)驗(yàn)室的重復(fù)程序標(biāo)準(zhǔn)化。在微觀領(lǐng)域里,單菌落的涂布和分離是任何微生物學(xué)和分子生物學(xué)研究過程中不可缺少的,盡管自動(dòng)化設(shè)備有明顯的好處,但在自動(dòng)機(jī)器人平臺(tái)上涂布細(xì)胞依然沒有被廣泛采用,很大程度上是由于目前機(jī)器人解決方案的不一致性和低通量造成的(一次涂布一個(gè)樣品)。但是如果一次處理數(shù)十萬個(gè)樣品,這明顯就不現(xiàn)實(shí)了。
SINGER公司針對(duì)這個(gè)問題開發(fā)了一個(gè)解決方案:整合優(yōu)化ROTOR+的高通量涂布程序,該程序?yàn)檠芯咳藛T提供在兩分鐘內(nèi)在單個(gè)平皿上涂布96個(gè)樣本的能力,這不僅節(jié)省寶貴時(shí)間和資源,也是一個(gè)真正的高通量的方法!
ROTOR+用定制針板涂布細(xì)胞
為了利用ROTOR+液體到瓊脂的轉(zhuǎn)移功能,SINGER開發(fā)了一種使用96密度長針RePads將細(xì)胞從96孔板轉(zhuǎn)移到瓊脂板的涂布方案。方案中,ROTOR+在一個(gè)矩形瓊脂平板上為96個(gè)樣品點(diǎn)種7×7矩陣,一旦ROTOR+從96孔板上取下樣品,它就會(huì)重復(fù)地在瓊脂板上定位點(diǎn)種,不需要返回來源板。隨著ROTOR+針尖的反復(fù)點(diǎn)種矩陣,針尖上的細(xì)胞被稀釋,這樣單菌落就形成了(圖1)。
圖片注釋:ROTOR+從96孔源板上蘸取菌液,點(diǎn)種到7×7矩陣的瓊脂板上。孵育后,所有96個(gè)樣品均可觀察到單個(gè)菌落
另一方面,為了評(píng)估ROTOR+涂布方案能夠涂布酵母和細(xì)菌細(xì)胞的有效性,將釀酒酵母培養(yǎng)過夜,對(duì)隔夜培養(yǎng)物進(jìn)行了2倍稀釋,并將細(xì)胞點(diǎn)種在Plusplate上(圖2a)。在30°C孵育48小時(shí)后,我們觀察到一系列稀釋后的單菌落。
涂布好的釀酒酵母在30°C孵育48小時(shí)
我們對(duì)畢赤酵母(圖2b)和大腸桿菌(圖2c)重復(fù)了相同的實(shí)驗(yàn),結(jié)果是一致的,我們觀察到在不同的稀釋倍數(shù)下單菌落的生長情況。這表明7×7矩陣涂布方案適用于一系列微生物,包括酵母和細(xì)菌細(xì)胞。
涂布好的畢赤酵母在30°C孵育36小時(shí)
涂布好的大腸桿菌在37°C孵育18小時(shí)
2倍連續(xù)稀釋結(jié)果表明,對(duì)于許多樣品,1:16到1:128稀釋會(huì)產(chǎn)生單個(gè)菌落。因此,我們用1:32稀釋的酵母隔夜培養(yǎng)重復(fù)了這個(gè)實(shí)驗(yàn),證實(shí)我們的結(jié)論。得到的圖像(圖3)顯示,每個(gè)樣本在其矩陣中都有明確的單個(gè)菌落,而且沒有菌落間的交叉污染。
將釀酒酵母隔夜培養(yǎng)物稀釋1:32,并將其涂在瓊脂上。培養(yǎng)皿在30℃下培養(yǎng)36小時(shí)
該方案還能涂布大腸桿菌轉(zhuǎn)化株細(xì)胞。大腸桿菌轉(zhuǎn)化是常見的實(shí)驗(yàn)方法,大量的轉(zhuǎn)化子需要被涂布以挑選單個(gè)菌落。為了確定ROTOR+的7×7陣列方法是否能夠涂布轉(zhuǎn)化后的大腸桿菌細(xì)胞,我們用a)編碼GFP的質(zhì)粒、b)空載體、c)不帶任何質(zhì)粒的dH2O轉(zhuǎn)化大腸桿菌。我們的數(shù)據(jù)表明,當(dāng)細(xì)胞用質(zhì)粒轉(zhuǎn)化時(shí),我們能夠在LB
+ Kan平板上獲得單菌落,而沒有質(zhì)粒轉(zhuǎn)化的細(xì)胞不能存活,不能在選擇性培養(yǎng)基上生長(圖4a)
為了測試轉(zhuǎn)化的特異性,我們使用能夠檢測GFP信號(hào)的PhenoBooth對(duì)平板進(jìn)行成像。正如預(yù)期的那樣,用GFP質(zhì)粒轉(zhuǎn)化的細(xì)胞顯示出強(qiáng)烈的GFP信號(hào),而用空載體轉(zhuǎn)化的細(xì)胞則沒有(圖4b)。
用GFP載體或空載體轉(zhuǎn)化的細(xì)胞在平板上形成菌落,而用水轉(zhuǎn)化的細(xì)胞不能形成菌落

用PhenoBooth對(duì)平板進(jìn)行紫外檢測,GFP信號(hào)成像。用GFP載體轉(zhuǎn)化的細(xì)胞形成帶有GFP信號(hào)的菌落,而用空載體轉(zhuǎn)化的細(xì)胞不能發(fā)出熒光
ROTOR+的7×7矩陣程序可以自動(dòng)化高通量地涂布微生物菌落形成單菌落,研究人員只需使用一個(gè)96長針RePad在不到兩分鐘的時(shí)間內(nèi)將96個(gè)樣品涂布在一個(gè)目標(biāo)板上。ROTOR+提供了一個(gè)真正的高通量和低成本的解決方案,只需1.25秒,極大的為科研節(jié)省了時(shí)間、資源和金錢。
ROTOR+的矩陣插件是一個(gè)很靈活強(qiáng)大的系統(tǒng),默認(rèn)的7×7矩陣是完全可以實(shí)現(xiàn)單菌落分離的,在整個(gè)自動(dòng)化流程中,搭配PIXL挑菌使用效果更佳。PIXL是一款極其可靠、易用的微生物菌落挑選工作站。自動(dòng)成像、識(shí)別、篩選、挑取菌落,從瓊脂平皿挑菌到瓊脂或到液體多孔板,也可從液體多孔板到瓊脂平皿。
如果您正在與不同的模式生物打交道,并希望嘗試這一開創(chuàng)性的技術(shù),請(qǐng)聯(lián)系我們。

關(guān)于我們
聯(lián)系我們

?2024 上海磐麥科技有限公司 版權(quán)所有 備案號(hào):滬ICP備20012062號(hào)-3